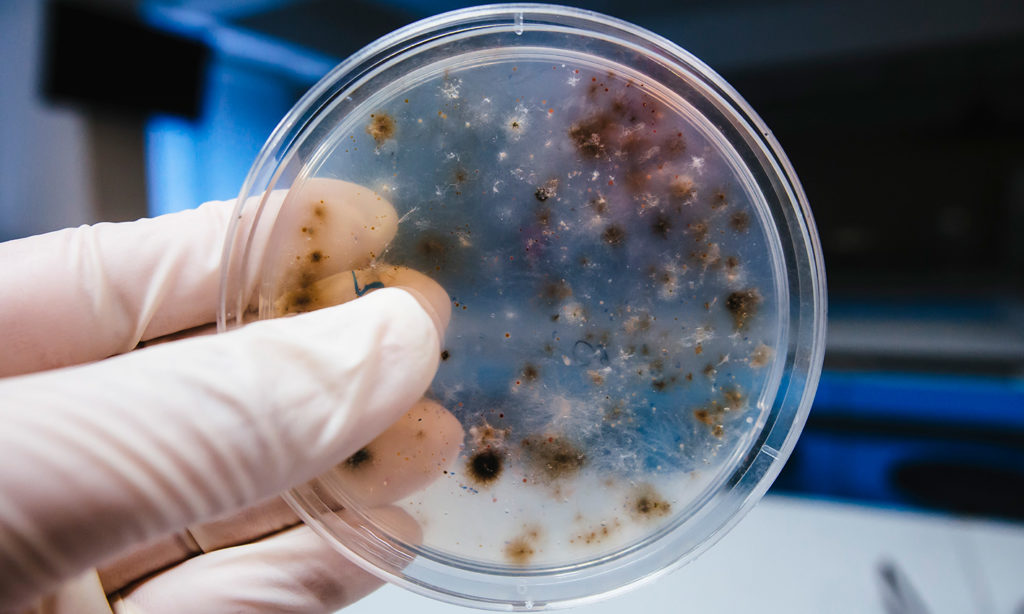
funghi

Bi-Ome
Tecnologia antimicrobica
ANTIMICROBICO, IGIENICO, FRESCO, ANALLERGICO, SALUTARE
CHE COS’È IL BI-OME:
Materassi e biancheria da letto sono inclini alla crescita microbica. Ciò costituisce un rischio per la salute delle persone e può causare reazioni allergiche. Gli insetticidi o i pesticidi possono facilmente uccidere le forme di vita microbiche, ma possono anche essere dannosi per le persone e l’ambiente.
È qui che entra in gioco BI-OME: una tecnologia antimicrobica non migrante, altamente efficace e non dannosa. Questo si traduce in una freschezza duratura e un’igiene notevolmente migliorata. BI-OME elimina con successo da materassi e biancheria da letto tutti microrganismi dannosi.

• ELIMINAZIONE DI MICRORGANISMI
Elimina tutti i tipi di microrganismi (batteri, alghe, funghi).
• ANALLERGICO
Elimina i funghi di cui gli acari della polvere si nutrono, fornendo così un effetto anti-allergenico.
• FRESCO E RESISTENTE
Freschezza duratura anche dopo più lavaggi multipli.
• SICURO ED ECOCOMPATIBILE
Non migrante e non dannoso per la pelle o l’ambiente.

FRESCHEZZA E IGIENE CON TECNOLOGIA ANTIMICROBICA
Performance
Grazie al non utilizzo di sostanze dannose, le persone e l’ambiente non vengono coinvolti. Mentre gli antimicrobici tradizionali perdono gradualmente la loro efficacia nel tempo, BI-OME rimane attiva per tutto il ciclo di vita dei prodotti trattati.
BATTERI:
Sono microrganismi viventi talvolta pericolosi per la nostra salute e si annidano in parti impensabili come materassi e lenzuola, ma che non vanno sottovalutati per non mettere a serio rischio noi e i nostri cari.
BATTERI:
Si tratta di speciali microrganismi che rappresentano sostanze organiche con dimensioni microscopiche, ma poco più grandi dei batteri. Talvolta presentano spore particolarmente resistenti e vivono nei tessuti come parassiti.
BATTERI:
Alti livelli di umidità dipendono dalla sudorazione corporea e favoriscono l’ideale coltura per funghi e quindi una vera e propria fonte di allergeni pericolosi per l’insorgere di possibili malattie allergiche, respiratorie e cutanee.

Acari della polvere
Gli acari della polvere sono invisibili ad occhio nudo, crescono nelle vostre case e si nutrono di cellule morte e residui di cibo. Preferiscono luoghi caldi, umidi come la biancheria da letto delle camere. Gli acari sono particolarmente coinvolti in malattie respiratorie (asma e rinite), ma anche in alcuni casi di infiammazione oculare o di focolai di eczema. Distruggendo gli acari e le loro uova, si consente lo sgombero sistematico di queste fonti di allergeni sui tessuti trattati.